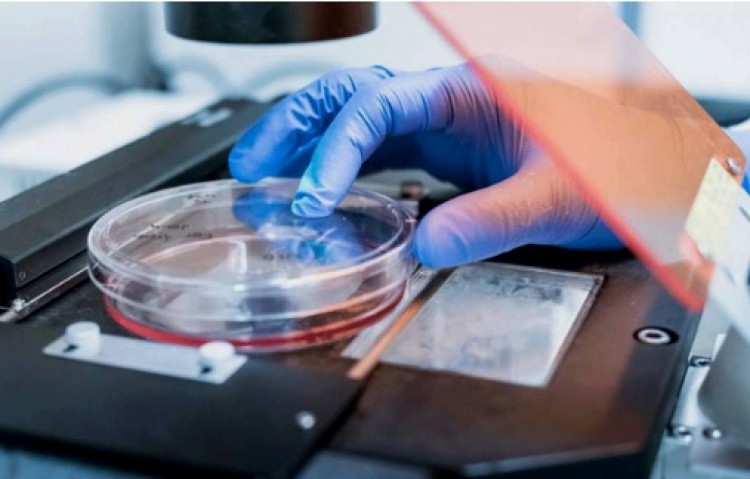

En el país, se registran unos 1.400 nuevos casos de melanoma, el cáncer de piel más agresivo. Desde hace un tiempo, este tumor está en aumento, lo mismo que la mortalidad. Si bien existen varias terapias farmacéuticas aprobadas en el mundo, no hay un fármaco que permita la prevención de esta patología. Por eso, hay entusiasmo luego del anuncio de investigadores nacionales, que están en una etapa avanzada para dar con un fármaco que permita la prevención del mal.Se trata de una vacuna que ya superó varias etapas de estudio, y que es la principal esperanza en estos días de dar con una solución que de esperanza a los pacientes. Marcela Barrio, médica investigadora del Conicet, aseguró en diálogo con la agencia estatal Télam que “tras cumplir con varias etapas” en el desarrollo de su investigación científica, “nos hallamos en la etapa final que nos permitiría validar los resultados”. Se trata de una vacuna que previene el cáncer de piel o melanoma, que afecta a la población y es considerado “uno de las manifestaciones más virulentas de cáncer”. “Hace más de 15 años estamos trabajando en un tratamiento de inmunoterapia para el cáncer, que en su momento fue pionero y hoy está en su apogeo en todo el mundo. Por lo tanto, hemos tenido mucha constancia en este proyecto”, agregó la investigadora. El proyecto consiste en el desarrollo “de vacunas para el melanoma, para el cual la mayoría de los tratamientos “no son efectivos”. En estos momentos, el fármaco se encuentra superando los estudios preclínicos, en modelos animales y clínicos.“Hemos desarrollado estudios de fase I y fase II, hemos terminado estos trabajos enteramente en el país”, agregó Barrio. Ahora, los investigadores preparan el estudio de fase III que les permita “dar la prueba final necesaria para saber si estas vacunas sirven para controlar la enfermedad, y lograr el registro posterior”. Este es el caso de melanoma, el tipo más grave de cáncer de piel, una afección que se origina justamente por la exposición a rayos UV provenientes del sol o del uso de cama solar y está muy relacionada con el tipo de piel de cada persona y sus antecedentes familiares. Este tipo de cáncer se caracteriza por el crecimiento descontrolado de las células que producen los pigmentos de la piel, pelo y ojos, los melanocitos. En el mundo, la incidencia del melanoma va en aumento y, puntualmente en Argentina, se registran más de 1.400 nuevos casos de pacientes al año, lo que representa el 1,3 por ciento de los casos de cánceres en total. Esto se traduce en 4 mil argentinos que padecen esta patología, de los cuales fallecen 574 personas anualmente, con tasas de mortalidad levemente mayores en hombres (351) que en mujeres (223). Para su tratamiento, existen varias opciones terapéuticas, muchos que se combinan. El año pasado, el país tendrá un nuevo medicamento para los pacientes que sufren este tipo de enfermedad. Se trata de un anticuerpo monoclonal aprobado por las autoridades sanitarias locales, para su versión metastásico. El producto ya fue autorizado por la FDA de Estados Unidos, y ahora tiene el visto bueno de la Administración Nacional de Medicamentos, Alimentos y Tecnología Médica (Anmat).Fuente: miradaprofesional.com
En el país, se registran unos 1.400 nuevos casos de melanoma, el cáncer de piel más agresivo. Desde hace un tiempo, este tumor está en aumento, lo mismo que la mortalidad. Si bien existen varias terapias farmacéuticas aprobadas en el mundo, no hay un fármaco que permita la prevención de esta patología. Por eso, hay entusiasmo luego del anuncio de investigadores nacionales, que están en una etapa avanzada para dar con un fármaco que permita la prevención del mal.Se trata de una vacuna que ya superó varias etapas de estudio, y que es la principal esperanza en estos días de dar con una solución que de esperanza a los pacientes. Marcela Barrio, médica investigadora del Conicet, aseguró en diálogo con la agencia estatal Télam que “tras cumplir con varias etapas” en el desarrollo de su investigación científica, “nos hallamos en la etapa final que nos permitiría validar los resultados”. Se trata de una vacuna que previene el cáncer de piel o melanoma, que afecta a la población y es considerado “uno de las manifestaciones más virulentas de cáncer”. “Hace más de 15 años estamos trabajando en un tratamiento de inmunoterapia para el cáncer, que en su momento fue pionero y hoy está en su apogeo en todo el mundo. Por lo tanto, hemos tenido mucha constancia en este proyecto”, agregó la investigadora. El proyecto consiste en el desarrollo “de vacunas para el melanoma, para el cual la mayoría de los tratamientos “no son efectivos”. En estos momentos, el fármaco se encuentra superando los estudios preclínicos, en modelos animales y clínicos.“Hemos desarrollado estudios de fase I y fase II, hemos terminado estos trabajos enteramente en el país”, agregó Barrio. Ahora, los investigadores preparan el estudio de fase III que les permita “dar la prueba final necesaria para saber si estas vacunas sirven para controlar la enfermedad, y lograr el registro posterior”. Este es el caso de melanoma, el tipo más grave de cáncer de piel, una afección que se origina justamente por la exposición a rayos UV provenientes del sol o del uso de cama solar y está muy relacionada con el tipo de piel de cada persona y sus antecedentes familiares. Este tipo de cáncer se caracteriza por el crecimiento descontrolado de las células que producen los pigmentos de la piel, pelo y ojos, los melanocitos. En el mundo, la incidencia del melanoma va en aumento y, puntualmente en Argentina, se registran más de 1.400 nuevos casos de pacientes al año, lo que representa el 1,3 por ciento de los casos de cánceres en total. Esto se traduce en 4 mil argentinos que padecen esta patología, de los cuales fallecen 574 personas anualmente, con tasas de mortalidad levemente mayores en hombres (351) que en mujeres (223). Para su tratamiento, existen varias opciones terapéuticas, muchos que se combinan. El año pasado, el país tendrá un nuevo medicamento para los pacientes que sufren este tipo de enfermedad. Se trata de un anticuerpo monoclonal aprobado por las autoridades sanitarias locales, para su versión metastásico. El producto ya fue autorizado por la FDA de Estados Unidos, y ahora tiene el visto bueno de la Administración Nacional de Medicamentos, Alimentos y Tecnología Médica (Anmat).Fuente: miradaprofesional.com






Discussion about this post